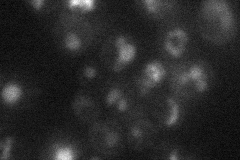
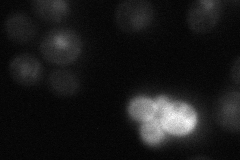

View description
Homeodomain-containing transcriptional repressor, binds to Mcm1p and to early cell cycle boxes (ECBs) in the promoters of cell cycle-regulated genes expressed in M/G1 phase; expression is cell cycle-regulated; potential Cdc28p substrate
Localization:
Intensity:
Fold change:
Significance:
-
C’ GFP library in SD

nucleus22.94 -
N' NOP1pr-GFP in SD

ER,punctate28.3418 -
N' TEF2pr-mCherry in SD
vacuole15.4755 -
N' NATIVEpr-GFP in SD
nucleus25.1637 -
N' TEF2pr-VC and Cyto-VN in SD

#N/A0 -
C’ GFP library in SD+DTT

nucleusN/AN/ANo -
C’ GFP library in SD+H2O2

nucleus20.180.87No -
C’ GFP library in Starvation Media

nucleus24.131.05No -
C’ GFP library on the background of Pup2-DaMP

nucleus -
C’ GFP library on the background of CCT mutant

nucleus24.63851.07373No
